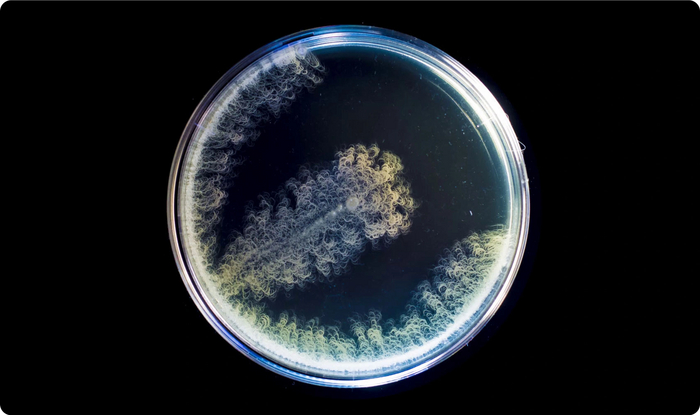

— Добрый день, хотим дизайн вот заказать для упаковки нашей продукции на маркетплейсах.
— Ой, ну это короче бюджет нужен.
— А по срокам как?
— Давайте сначала ТЗ составим, а там уже и сроки почувствуем.
Примерно так происходит начало общения с большинством дизайн-студий при поиске без знакомств, просто в интернете.
В чём проблема?
Так это же не картинки в интернете рисовать, тут надо искать тару (прямо флаконы, да), общаться с поставщиками, чтобы не зарядили опт. от 10 000 флаконов минимальная партия, под эту тару померить габариты, придумать дизайн, вписать дизайн, найти типографию, напечатать цветопробу ( — Ого, картинки не в браузере, а в руках можно подержать!), сделать правки в макете, снова напечатать и как будет готово — представить финальный проект.
А теперь представьте, сколько людей в этом задействовано, каждый на зарплате, даже когда работы нет, а за всё это платите в итоге вы. Можно фрилансера нанять, но шансов получить в срок качественную работу без классических «интернет отключили, завтра с утра отправлю» в лучшем случае 50:50, а если не фортануло, то время уже не отмотаешь назад, это вам не TENET.
Как говорится, не пытайся понять, почувствуй.
Хотя по степени выноса мозга оба процесса примерно одинаковы.
Так, а что делать?
Зависит от ситуации. Наша компания на текущий момент работает с крупными предприятиями в промышленных объёмах: поставляем в еврокубах по тонне и канистрах 10 литров. Удобно для агрохолдингов, неудобно для домашнего пользования. Надо придумать упаковку для маркетплейсов, но и переплачивать на старте за эксперимент не хочется, а слушать нытьё дизайнеров «я художник, я так вижу, вот ещё 3 правки и мы всё» тоже нет времени и желания.
А что же нейросети?
Вокруг так много шухера про них, каждые полгода что-то новое появляется. Может, попробовать с их помощью нагенерить дизайн и обойтись малой кровью?
А что другие компании? Может, кто-то уже делал?
Ну да. Только что.
Насмотревшись абстрактных пейзажей и натюрмортов, которые крупные компании лепят на продукцию и сразу пишут «упаковка сделана нейросетями», как-то совсем уныло становится от осознания того, насколько скупо раскрывается потенциал нейросетей. С таким же успехом можно было на Старом Арбате стрельнуть фотки картин пары местных уличных художников и пустить в продакшн.
Нейросеть — ваша личная дизайн-студия, говорили они.
Вот мы и решили проверить, насколько сочную упаковку cможет предложить нейросеть, не забыв при этом про смысл.
Начнём.
Шаг номер 1: изучите ваш продукт.
Мы являемся производителем микробиологических препаратов для растений и биопрепаратов для переработки органических отходов в чернозём.
Логичный вопрос: что это и зачем оно вообще надо. Если коротко — мы культивируем штаммы природных чернозём-образующих полезных микроорганизмов, которые помогают растению лучше усваивать питательные вещества из почвы, повышая урожайность, укрепляя иммунитет и снижая уровень нитратов в плодах, то есть возвращается вкус и аромат.
Когда-нибудь задумывались над вопросом: как питается растение? Ожидаемо, всё начинается в почве. Вот как выглядит корневая система будущего растения в первые дни роста.
Один оборот света — сутки.
При желании можно включить звук для музыкального сопровождения.
По сути принцип питания растений и человека один и тот же: есть питательные вещества и есть полезные бактерии. Микроорганизмы в микрофлоре расщепляют еду до простейших форм для легкого усваивания микроэлементов через поры корней у растений или слизистой желудочно-кишечного тракта у человека. Если нарушить микробиоту, то всасывание питательных веществ ухудшается, нарушается обмен веществ и в итоге мы имеем болезненное растение/человека, как бы хорошо ни кормили.
А какой должна быть здоровая микробиота в почве?
На рынке множество микробиологических препаратов, но чаще всего это монокультуры. То есть, к примеру, продали вам Azotobacter, который отвечает за фиксацию азота в почве. Вот внесли его на поле, а результата не увидели. Почему так?
Таким сложным семействам бактерий требуется от трёх до пяти дней на формирование первых колоний. Проблема в том, что в почве полным полно других микроорганизмов и патогенов, отчего вероятность того, что Azotobacter в одиночку сможет противостоять армии «плохих» бактерий в почве, невелика. Поэтому часто бывает ситуация, когда фермер тратит деньги на покупку микробиологического препарата с монокультурой Azotobacter для улучшения усвояемости азота: льёт на поле, монокультуру давит патоген в почве, агроном не видит результата и говорит, что всё это развод, деньги на ветер, чёртовы кидалы.
А всего-то надо было подготовить благоприятную микрофлору предварительно. Что и происходит в природе в чернозёме: сначала начинают работать антипатогенные Bacillus mycoides. Обратите внимание, как на видео ниже из очага размером с каплю всего за сутки колония распространяется на площадь в тысячу раз больше первоначальной.
Потом на второй день подключается Bacillus subtilis, мощная антипатогенная сенная палочка, которая при формировании колоний поедает более сложные формы патогенной микрофлоры и создаёт благоприятный микробиологический фон.
И вот уже в этой биологически благоприятной флоре начинают свой рост более высокоорганизованные культуры полезных бактерий, которые отвечают за выработку естественных гормонов роста, антиоксидантов и витаминов, как тот же Azotobacter.
Так уж устроена природа: чем более сложные компоненты производит микроорганизм, тем он более уязвим перед патогенами. Присмотритесь за скоростью роста антипатогенных колоний Bacillus mycoides и Bacillus subtilis по сравнению с Azotobacter chroococcum.
И это только самые многочисленные семейства из всего многообразия. В центре же представлен общий микробиологический фон микрофлоры чернозёма, где все микроорганизмы и метаболиты уживаются в симбиозе, когда колонии не подавляют, а наоборот помогают друг другу.
Важно отметить, что эти процессы отлажены природой за миллиарды лет и мы не создаём ничего нового. Мы лишь бережно собираем микрофлору эталонного органически чистого чернозёма, консервируем её специальным образом с контролем качества, чтобы в спящей стабильной форме передать фермеру с проблемной почвой для восстановления её микрофлоры и повышения урожая.
А проблемной почвы сегодня много. Очень много.
Если на заре интенсивного земледелия в 1970-ых ресурс микробиоты почвы позволял давать большие урожаи, то за более чем полвека обработки агрессивными агрохимиками почвенная микробиота истощилась настолько, что деградация почв носит уже стихийный характер.
Учитывая обилие химических удобрений, пестицидов, гербицидов, семена сегодня раскрывают свой потенциал урожайности в большинстве случаев лишь на 60-70%. Дело в том, что у семени запасено ограниченное количество энергии, которое оно должно направить в первые дни роста на формирование зачатков сильной будущей корневой системы. Но из-за перенасыщения химии в почве и нарушенного pH, большая часть этой энергии расходуется на борьбу с этой самой негативной средой вокруг и восстановление от химических ожогов.
Если же почву предварительно обработать чернозём-образующими микроорганизмами, то семя, будучи в комфортных условиях, с первых же дней сможет направить 100% своей энергии только на формирование сильной корневой системы вместо борьбы с патогенной флорой — а это залог здорового, крепкого растения в будущем.
— Патоген-патоген, что ещё за патоген?
Грибок, например. Распространители корневых гнилей, которых можно занести на урожай на подошве ботинок? Фузариоз с зараженного семени?
Страшные слова для любого фермера. И если до недавнего времени единственным способом борьбы с ними были химикаты, то сегодня есть альтернатива: систематическое формирование иммунитета у почвы. Да-да, почва как большой организм способна сама бороться с большинством видов заразы: миллиарды лет идёт борьба между царством грибов и микроорганизмов, как отлаженный механизм. То, что мы этого не замечаем — сугубо наша проблема.
А технологии позволят нам поближе рассмотреть эту борьбу. В приведённом ниже примере представлен антагонизм почвенных микроорганизмов по отношению к Bipolaris sorokoniana — возбудителем корневых гнилей у зерновых культур. Тут же можно рассмотреть, как с разной скоростью формируются разные колонии полезных почвенных микроорганизмов.
Для наглядности можно сравнить, как разные концентрации бактерий борются с очагом грибка.
Видно, что даже 1% ризосферных микроорганизмов в среде способно успешно бороться с возбудителем корневых гнилей, не позволив грибку распространиться до края среды.
Мы рекомендуем делать минимум 2% раствор с водой, чтобы систематически формировать иммунитет у почвы.
Расширим пример на 3 наиболее популярных в наших широтах патогена:
1. Bipolaris sorokiniana — возбудитель корневых гнилей у зерновых культур.
2. Fusarium oxysporum — фузариоз зерновых культур.
3. Alternaria alternata — возбудитель гнилей у салатов и овощей.
Грибок, засуха, заморозки — эти факторы появляются чаще всего из ниоткуда и в эти дни фермер особенно переживает за растения. Ведь теряя урожай, люди чаще всего теряют единственный по-настоящему ценный ресурс — время.
В таких случаях сильная и глубокая корневая система со здоровой микрофлорой играет не последнюю роль в способности растению противостоять как можно дольше шоковым факторам и скорее восстановиться после критических уровней гибернации.
К слову, данные видео являются частью RnD по разработке системы контроля качества, которая с помощью компьютерного зрения, кадрам с 360° в требуемых спектрах и машинному обучению проверяет каждую партию на соответствие эталонному, сопоставляя вектора и форму роста колоний микроорганизмов в течение времени для определения конкретных штаммов и их концентрации. Для этого также было разработано специальное ПО и оборудование, позволяющее запечатлеть динамику роста колоний в течение нескольких суток. Но там материала на отдельную статью.
Итого: какой у нас продукт?
Обязательно стоит указать, что микрофлора Marvel Organics полностью безопасна для человека, домашних животных и окружающей среды. Препарат прошёл испытания в Министерстве Сельского хозяйства РФ и имеет сертификат государственной регистрации. Без этого можно даже не начинать — это первое, что стоит сделать перед тем, как идти продавать удобрения.
Жидкий концентрат, который надо разбавлять в определенной пропорции с водой перед применением.
Обязательно вносить методом распыления.
Кислород в капельках пробуждает полезные микроорганизмы.
Повышает урожайность благодаря формированию более глубокой сильной корневой системы.
Стимулирует цветение и улучшает вкус плодов благодаря стабилизации обмена веществ и выработке натуральных гормонов роста, витаминов, антиоксидантов, что также снижает уровень накопленных нитратов.
Ах да, если увеличить концентрацию сенной палочки Bacillus sublitis, то можно получить биопрепарат для переработки органических отходов: птичий помёт, коровий навоз, овощная некондиция — всё это можно использовать для создания чернозёма всего за 3 недели.
Повышает иммунитет почвы, благодаря чему снижается вероятность заражения урожая грибком.
Структура колоний полезных микроорганизмов залипательно фрактальная :)
Формирование концепции будущей линейки
Количество продуктов
3 продукта для полного цикла растениеводства:
Биопрепарат для создания органически чистой почвы из органических отходов.
Удобрение для овощей и фруктов в огороде.
(Можно получить органически чистый урожай без химикатов на почве из первого пункта.)
Удобрение для цветов.
Объём тары
С рекомендуемыми дозировками наиболее оптимальным выбором будет белый флакон 500 мл. — этого хватит на один сезон для типичного дачного участка. Тем более, что нам удалось найти очень хорошего поставщика, который поставляет партиями кратно 100 шт. (вы не поверите, но это правда большая удача найти симпатичный аккуратный флакон, отпускаемый малыми партиями).
Дизайн
Осталось дело за малым — cделать красиво.
Для работы воспользуемся двумя топовыми нейросетями:
Midjourney — для генерации визуализаций.
ChatGPT — для редактуры текста наклейки.
Ну и базовые знания фотошопа по двиганию слоёв текста и картинок. Не будем фокусироваться на технических деталях регистрации и начала работы с нейросетями, в интернете полно инструкций на любой вкус и кошелёк. В нашем случае стандартный план Midjourney обошёлся в 30 долларов, а ChatGPT и так бесплатный.
— Ну что, попробуем сделать дизайн на миллион долларов за 3 000 рублей?
Работу выстроим по следующей схеме:
Определимся с дизайн-кодом флаконов (расположение логотипа, инструкции, технической информации).
Сформулируем для себя ТЗ по визуальным образам для каждого флакона и сгенерируем изображения.
С помощью ChatGPT запихнём кучу текста в ограниченное пространство этикетки.
Рекомендую специально начинать с наиболее абстрактных интуитивных этапов, чтобы не закопаться в деталях с самого старта и не потерять интерес. Это особенно актуально, когда у вас синдром чистого листа и не знаете с чего вообще начать.
Так как на Пикабу можно приложить только 25 медиафайлов в одну публикацию, длиннопост поделён на серию из несколько глав.